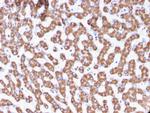
Prohibitin (Mitochondrial Marker) Antibody in Immunohistochemistry (Paraffin) (IHC (P))

Search
NeoBiotechnologies
Prohibitin (Mitochondrial Marker) Monoclonal Antibody (PHB/3229)
{{$productOrderCtrl.translations['antibody.pdp.commerceCard.promotion.promotions']}}
{{$productOrderCtrl.translations['antibody.pdp.commerceCard.promotion.viewpromo']}}
{{$productOrderCtrl.translations['antibody.pdp.commerceCard.promotion.promocode']}}: {{promo.promoCode}} {{promo.promoTitle}} {{promo.promoDescription}}. {{$productOrderCtrl.translations['antibody.pdp.commerceCard.promotion.learnmore']}}
产品信息
5245-MSM9-P1ABX
种属反应
宿主/亚型
分类
类型
克隆号
抗原
偶联物
形式
浓度
纯化类型
保存液
内含物
保存条件
运输条件
靶标信息
Prohibitin is from an evolutionarily conserved gene that is ubiquitously expressed. It is thought to be a negative regulator of cell proliferation and may be a tumor suppressor. Mutations in PHB have been linked to sporadic breast cancer. Prohibitin is expressed as two transcripts with varying lengths of 3' untranslated region. The longer transcript is present at higher levels in proliferating tissues and cells, suggesting that this longer 3' untranslated region may function as a trans-acting regulatory RNA.
仅用于科研。不用于诊断过程。未经明确授权不得转售。
篇参考文献 (0)
生物信息学
蛋白别名: epididymis luminal protein 215; epididymis secretory sperm binding protein Li 54e; OTTHUMP00000165765; OTTHUMP00000165766; OTTHUMP00000220103; OTTHUMP00000220170; OTTHUMP00000220171; Prohibitin 1
基因别名: HEL-215; HEL-S-54e; PHB; PHB1
UniProt ID: (Human) P35232
Entrez Gene ID: (Human) 5245